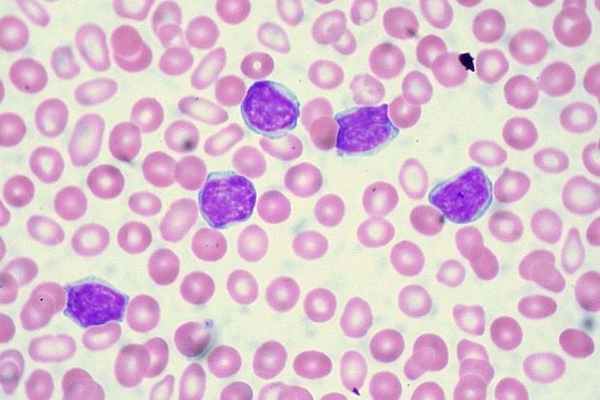
Стадии острого лимфобластного лейкоза

Острый лимфобластный лейкоз
Добавил пользователь Skiper Обновлено: 27.01.2026
Лейкоз, или лейкемия — заболевание кроветворной системы, в обиходе иногда называемое «раком крови». При лейкозе в костном мозге производится избыточное количество аномальных незрелых клеток крови, обычно предшественников лейкоцитов. Эти бластные клетки, размножаясь и накапливаясь в костном мозге, мешают выработке и функционированию нормальных клеток крови, что и обусловливает основные симптомы заболевания. Кроме того, эти опухолевые клетки могут накапливаться в лимфоузлах, печени, селезенке, центральной нервной системе и других органах, также вызывая появление специфических симптомов.
Как известно, различные клетки крови развиваются по-разному и имеют разных предшественников — то есть относятся к различным линиям кроветворения (см. схему в статье «Кроветворение»). Линия кроветворения, приводящая к появлению лимфоцитов, называется лимфоидной; остальные же лейкоциты относятся к миелоидной линии. Соответственно, различают лейкозы из клеток-предшественников лимфоцитов (такие лейкозы называют лимфобластными, лимфоцитарными или просто лимфолейкозами) и из предшественников других лейкоцитов (миелобластные, миелоидные, миелолейкозы).
Острый лимфобластный лейкоз (ОЛЛ) — самый распространенный вид лейкоза у детей, но это заболевание встречается и во взрослом возрасте. Термин «острый» означает быстрое развитие болезни, в противоположность хроническому лейкозу. Термин «лимфобластный» означает, что незрелые клетки, составляющие основу болезни, являются лимфобластами, то есть предшественниками лимфоцитов.
Частота встречаемости и факторы риска
На долю ОЛЛ приходится 75-80% всех опухолевых заболеваний кроветворной системы у детей и примерно 25% всех детских онкозаболеваний вообще (примерно 4 случая на 100 тысяч детей в год). Именно ОЛЛ — самое распространенное онкологическое заболевание у детей. Чаще всего ОЛЛ возникает в возрасте до 14 лет; пик детской заболеваемости приходится на возраст 2-5 лет. У мальчиков эта болезнь встречается немного чаще, чем у девочек.
Вероятность возникновения ОЛЛ несколько повышена у людей, ранее получавших лечение от какой-либо другой болезни (обычно злокачественной опухоли) с использованием облучения или определенных видов цитостатической химиотерапии. Также риск ОЛЛ повышен у детей с некоторыми генетическими нарушениями — например, с синдромом Дауна, нейрофиброматозом типа I или рядом первичных иммунодефицитных состояний.
Риск заболеть для ребенка выше среднего, если у его брата- или сестры-близнеца уже был диагностирован лейкоз. Другие случаи, когда в одной и той же семье ОЛЛ возникает более чем у одного ребенка, бывают, но исключительно редки.
Впрочем, в большинстве случаев ОЛЛ не удается обнаружить никакого известного фактора риска, и причины, вызвавшие болезнь, остаются неизвестными.
Признаки и симптомы
ОЛЛ характеризуется множеством различных признаков и у разных больных может проявляться совершенно по-разному. Большинство наблюдаемых симптомов, однако, обусловлено тяжелыми нарушениями кроветворения: избыток аномальных бластных клеток при ОЛЛ сочетается с недостаточным количеством нормальных функциональных клеток крови.
Обычно наблюдаются слабость, бледность, снижение аппетита, потеря веса, учащенное сердцебиение (тахикардия) – проявления анемии и опухолевой интоксикации. Недостаток тромбоцитов проявляется мелкими кровоизлияниями на коже и слизистых оболочках, кровотечениями из десен, носовыми и кишечными кровотечениями, кровоподтеками, синяками. Из-за накопления бластных клеток часто увеличиваются лимфоузлы — в частности, шейные, подмышечные, паховые. Нередко увеличиваются также печень и селезенка - как говорят, возникает гепатоспленомегалия.
Часто наблюдаются боли в костях и суставах, иногда возникают патологические (то есть вызванные заболеванием) переломы костей. Из-за недостаточного количества нормальных зрелых лейкоцитов возможны частые инфекции. Повышение температуры может наблюдаться как в связи с возникшей на фоне лейкоза инфекцией, так и из-за опухолевой интоксикации. Иногда одним из проявлений острого лейкоза является продолжительная ангина, плохо поддающаяся терапии антибиотиками.
В некоторых случаях ОЛЛ вызывает изменения и в других органах: глазах, почках, яичках у мальчиков и яичниках у девочек, причем у мальчиков поражение половых органов наблюдается чаще. Может возникнуть поражение центральной нервной системы — нейролейкемия.
Так как все наблюдаемые симптомы могут быть связаны и с другими заболеваниями и не специфичны для ОЛЛ, перед началом лечения необходима лабораторная диагностика, которая в срочном порядке производится в больничных условиях.
Диагностика
При ОЛЛ возникают изменения в обычном клиническом анализе крови: как правило, понижены уровни эритроцитов и тромбоцитов, появляются бластные клетки. Очень высокий лейкоцитоз (гиперлейкоцитоз) возможен, но, вопреки распространенному мнению, наблюдается далеко не во всегда. В целом же надежно поставить диагноз можно только при исследовании образца костного мозга; для этой цели необходима костномозговая пункция.
При морфологическом исследовании диагноз «острый лимфобластный лейкоз» ставится при обнаружении более 25% бластных клеток в костном мозге (в противном случае речь может идти о лимфобластной лимфоме). Но обязательно производятся более тонкие исследования: цитохимическое (окрашивание клеток, позволяющее более точно установить их природу), цитогенетическое (изучение строения хромосом в лейкемических клетках), иммунофенотипирование (изучение белковых молекул-маркеров, находящихся на поверхности клеток). Дело в том, что при диагностике очень важно не только надежно отличить ОЛЛ от острого миелоидного лейкоза, но и определить конкретный вариант ОЛЛ, поскольку он сильно влияет на терапию и прогноз заболевания.
Так, ОЛЛ может быть B-клеточным (около 80% случаев) и T-клеточным, в зависимости от того, относятся ли лейкемические клетки к B- или T-лимфоцитарной линии. В зависимости от «степени зрелости» бластных клеток выделяют несколько вариантов среди как В-, так и Т-клеточных лейкозов; их установление методом иммунофенотипирования важно для определения стратегии лечения. Существенны для назначения терапии цитогенетические особенности опухолевых клеток (см. ниже).
В ходе диагностики ОЛЛ также необходимо исследовать состояние центральной нервной системы. Анализ спинномозговой жидкости (ликвора) позволяет определить, нет ли у больного поражения центральной нервной системы — нейролейкемии. Образец ликвора для анализа получают посредством пункции спинномозгового канала.
Возможны и дополнительные диагностические процедуры для исследования пораженных лимфоузлов и внутренних органов — компьютерная томография (КТ), ультразвуковое исследование (УЗИ) и так далее.
Диагностические исследования позволяют для каждого конкретного больного определить ту или иную группу риска, от которой зависят прогноз заболевания и планируемое лечение. Так, говорят о стандартном, промежуточном, высоком риске и т. д. Отнесение к той или иной группе в рамках конкретного протокола лечения зависит от многих факторов. Перечислим некоторые из них.
Возраст больного: менее благоприятным считается возраст до 1 года или старше 10 лет.
Количество лейкоцитов: риск увеличивается при очень высоком лейкоцитозе в момент постановки диагноза.
Распространение ОЛЛ в другие органы, помимо костного мозга (например, возникновение нейролейкемии), определяет более высокий риск.
При раннем или повторном рецидиве риск повышается.
Кроме того, выбор стратегии лечения зависит от варианта лейкоза (В- или Т-клеточный ОЛЛ), а также от цитогенетических аномалий в лейкемических клетках, связанных с числом хромосом и транслокациями. Некоторые из них достоверно влияют на течение болезни и ход терапии, другие только изучаются. Так, филадельфийская хромосома — транслокация t(9;22) — требует подключения к терапии дополнительных таргетных лекарств. Транслокация t(4;11) часто требует трансплантации костного мозга. В то же время, например, транслокация t(12;21) обычно связана с относительно хорошим прогнозом.
Лечение
Как упомянуто в предыдущем разделе, современное лечение ОЛЛ основано на разделении пациентов на группы риска — в зависимости от того, насколько вероятно у них достижение и сохранение ремиссии при одинаковой терапии. Соответственно, пациенты, относящиеся к группам более высокого риска (то есть те, у кого изначальный прогноз хуже), получают более интенсивную терапию, а в группах более низкого риска можно использовать менее интенсивную терапию и тем самым избегать излишней токсичности и тяжелых осложнений.
Терапия ОЛЛ, как правило, состоит из трех этапов:
Индукция ремиссии (то есть терапия, направленная на достижение ремиссии) проводится в течение нескольких первых недель лечения. Под ремиссией здесь подразумеваеся содержание менее 5% бластных клеток в костном мозге и отсутствие их в обычной (периферической) крови в сочетании с признаками восстановления нормального кроветворения.
В ходе индукции проводится интенсивная многокомпонентная химиотерапия лекарствами-цитостатиками, которые вызывают разрушение лейкемических клеток. На этом этапе могут применяться, в зависимости от протокола, такие лекарства, как гормоны-глюкокортикостероиды, аспарагиназа и пэгаспаргаза, винкристин, даунорубицин, другие препараты. Индукция позволяет достигнуть ремиссии более чем у 95% детей и у 75-90% взрослых с ОЛЛ. Принципиально важно посредством лабораторных анализов оценить ответ на терапию индукции: в случае плохого ответа (к контрольному сроку не удалось достичь нужных результатов) пациент переводится в группу более высокого риска.
Консолидация (закрепление) ремиссии направлена на уничтожение остаточных аномальных бластных клеток во избежание рецидива заболевания. Общая продолжительность этого этапа измеряется месяцами и сильно зависит от конкретного протокола лечения. В ходе курсов терапии на этапе консолидации могут использоваться, опять-таки в зависимости от конкретного протокола, метотрексат, аспарагиназа, 6-меркаптопурин, винкристин, глюкокортикостероиды, даунорубицин и ряд других лекарств в зависимости от протокола и терапевтической группы.
На этапах индукции и консолидации введение химиотерапевтических препаратов производится в основном внутривенно, в условиях больничного стационара или стационара одного дня.
Поддерживающая терапия проводится для поддержания ремиссии, то есть для дополнительного снижения риска рецидива после этапов индукции и консолидации. Продолжительность поддерживающей терапии — полтора-два года. На этом этапе основными препаратами являются 6-меркаптопурин и метотрексат.
Поддерживающая терапия представляет собой этап наименее интенсивного лечения. Ребенок живет дома, постоянное пребывание или ежедневные визиты в больницу не требуется.
Существует также понятие реиндукции: это периодически повторяемые уже после достижения ремиссии циклы интенсивной полихимиотерапии. Реиндукция позволяет дополнительно снизить число лейкемических клеток и тем самым повысить «надежность» ремиссии.
Если требуется лечение или профилактика нейролейкемии на перечисленных этапах, химиопрепараты вводятся интратекально, то есть в спинномозговой канал посредством люмбальных пункций. Иногда лекарства вводят в желудочки (особые полости) головного мозга через специальный резервуар Оммайя, который устанавливается под кожей головы. Для интратекального введения при ОЛЛ используются метотрексат, цитарабин и гормоны-глюкокортикостероиды. У некоторых пациентов применяется и облучение головы — краниальное облучение.
К сожалению, несмотря на все перечисленные меры, иногда возникает рецидив ОЛЛ — костномозговой, экстрамедуллярный (то есть вне костного мозга — например, с поражением центральной нервной системы или яичек) или комбинированный. В этом случае проводится противорецидивная терапия. Выбор метода лечения рецидива зависит от сроков его возникновения (ранний или поздний) и от того, является ли рецидив костномозговым или экстрамедуллярным. При раннем рецидиве шансы на успех одной только лекарственной терапии значительно снижаются и практически всегда планируется трансплантация.
В ходе лечения ОЛЛ может применяться трансплантация костного мозга от родственного или неродственного донора. Если по плану лечения предусмотрена трансплантация, то ее проводят после достижения ремиссии. Как правило, трансплантация показана только при высоком риске (например, после раннего рецидива или при плохом ответе на терапию индукции), поскольку это очень тяжелое лечение, а хорошие результаты стандартной терапии при ОЛЛ в среднем вероятны, особенно у детей.
Химиотерапия ОЛЛ высокоэффективна, но зачастую тяжело переносится и может быть связана с серьезными побочными эффектами. Так, в процессе лечения подавляется кроветворение и бывают необходимы переливания компонентов донорской крови — тромбоцитов во избежание кровотечений при очень низком уровне собственных тромбоцитов больного, эритроцитов для борьбы с анемией. Переливания донорских гранулоцитов применяются только в редких случаях при тяжелых инфекционных осложнениях.
В числе «обычных» побочных эффектов химиотерапии можно также назвать тошноту, рвоту, облысение. Серьезнае проблема связана с возможностью аллергических реакций на химиопрепараты, вплоть до анафилактического шока — жизнеугрожающего состояния, которое характеризуется отеком, затруднением дыхания, сильным зудом и т.д. Так, сравнительно часто встречается аллергия на аспарагиназу, и может быть необходимо использование аналогов этого препарата («Онкаспар», «Эрвиназа»).
Поскольку и лейкоз сам по себе, и используемая при его лечении химиотерапия резко снижают сопротивляемость организма различным инфекциям, больным во время лечения необходимы эффективные антибактериальные и противогрибковые лекарства для профилактики и терапии инфекционных осложнений. Опасны как обычные, так и оппортунистические инфекции.
Интенсивное лечение ОЛЛ накладывает серьезные ограничения на образ жизни больного. Необходимо соблюдать определенную диету и строгие гигиенические требования. Во избежание инфекций ограничиваются контакты с внешним миром. При очень низком уровне тромбоцитов нельзя не только допускать травмы, но даже, например, чистить зубы зубной щеткой, чтобы не спровоцировать кровотечение из десен. После достижения ремиссии строгость этих ограничений постепенно снижается. Врачи и медсестры сообщают каждому больному, что ему можно и что нельзя на текущем этапе лечения.
В последние годы появилось несколько новых возможностей лечения даже самых сложных случаев ОЛЛ. Особо следует отметить иммунопрепараты «Блинцито» (блинатумомаб) и «Биспонса» (инотузумаб озогамицин), а также CAR T-клеточную терапию, применяемые при В-клеточном ОЛЛ. Есть и специальные препараты для Т-клеточного ОЛЛ, такие как «Атрианс» (неларабин). Иногда применяется также «Эвольтра» (клофарабин). Некоторым больным помогает включение в терапию препарата «Велкейд» или «Бартизар» (бортезомиб). Есть и другие варианты.
Прогноз
Без лечения ОЛЛ приводит к гибели больного в течение нескольких месяцев. Однако использование современных протоколов лечения дает при ОЛЛ очень хороший результат: можно вылечить 85-90% больных детей. У взрослых, особенно пожилых, результаты хуже, но, тем не менее, примерно у 40% взрослых больных удается достичь долговременной ремиссии — то есть отсутствия рецидивов болезни в течение многих лет.
Острый лимфобластный лейкоз

Острый лимфобластный лейкоз – это злокачественная патология костного мозга и крови, которая заключается в продуцировании кроветворным органом бластных (незрелых) лейкоцитов. Эти клетки неспособны выполнять свою функцию и постепенно вытесняют нормальные клетки, что приводит к катастрофическому падению иммунитета, анемии, инфекционным воспалительным процессам, кровотечениям и другим нарушениям нормальной жизнедеятельности организма. Заболевание развивается очень быстро и при отсутствии квалифицированной медицинской помощи в течение нескольких месяцев приводит к летальному исходу.
Общепринятая классификация острых лимфобластных лейкозов (ОЛЛ) подразделяет их на две группы, в зависимости от типа пораженных лейкоцитов.
- В-клеточный (до 85% всех случаев) наиболее характерен для детского возраста, причем пик заболеваемости приходится на 3-й год жизни. Взрослые заболевают крайне редко. Вторая группа риска – это люди старше 60 лет, но среди пожилых людей заболеваемость в 5-6 раз ниже, чем у детей
- Т-клеточный (15-20% случаев) характеризуется более тяжелым течением и высокой агрессивностью. Наибольшее количество заболевших приходится на 15-летний возраст.
Патологическая мутация В-лейкоцитов и Т-лейкоцитов может происходить на разных этапах созревания. Если в крови появляются недозрелые клетки, мутировавшие на начальных этапах, то к названию формы лейкоза добавляют приставку «пре». Это отличает лимфоцитарные онкопатологии от острого нелимфобластного лейкоза, при котором такого разделения нет.
Симптомы
Первые проявления острого лимфоидного лейкоза неспецифичны и характерны для многих заболеваний:
- бледность кожных покровов из-за развивающейся анемии;
- вялость, упадок сил, сонливость;
- частые инфекционные заболевания из-за снижения иммунитета;
- повышенная температура тела.
С развитием болезни, увеличением в крови количества бластных лимфоцитов и недостатком здоровых клеток появляются более выраженные симптомы:

- кровоточивость слизистых оболочек;
- синяки, точечные кожные кровоизлияния;
- длительное заживление даже небольших царапин и ранок, сопровождающееся инфицированием, воспалениями, нагноениями;
- боли в конечностях, вызванные ростом опухоли костного мозга;
- увеличение размеров печени, селезенки, лимфоузлов, приводящие к болям в животе;
- затрудненное дыхание, одышка;
- паралич лицевого нерва, ухудшение зрения, рвота из-за поражения мозговых оболочек.
В каждом отдельном случае формируется индивидуальный симптомокомплекс, в который перечисленные признаки могут входить частично или полностью.
Причины и факторы риска
Непосредственной причиной заболевания всегда становится злокачественная мутация клеток кроветворной системы, из-за которой они становятся способны к быстрому бесконтрольному размножению. Существует предположение, что изменение генома происходит еще во время внутриутробного развития, но до определенного момента процесс остается незавершенным. «Спусковым крючком» нередко становятся внешние обстоятельства:
- радиоактивное излучение любой природы, в том числе во время лечения других форм рака;
- некоторые химические соединения – бензол, определенные препараты химиотерапии;
- вирусные инфекции (Эпштейна-Барр, HTLV);
- унаследованная предрасположенность.
Острый лимфоцитарный лейкоз часто развивается у детей, реже – у людей старше 60 лет, совсем редко – у взрослых. Представители белой расы заболевают чаще темнокожих, мужчины – несколько чаще женщин.
Стадии
Поскольку при онкозаболеваниях крови опухоль, как таковая, не развивается, то общие критерии стадийности для оценки их течения не подходят. Начальной стадией острого лимфобластного лейкоза считают период от появления злокачественного клона до появления выраженных симптомов. Далее выделяют следующие этапы.
- Первая атака, или дебют. В это время заболевание стремительно развивается, пациент обращается к врачу, его помещают в гематологический стационар и проводят индукционную терапию.
- Ремиссия. Она может быть полной, со снижением уровня бластных лейкоцитов менее 5% и наличием в миелограмме всех здоровых ростков кроветворения, и частичной, при которой улучшение показателей крови является временным и через определенный период прекращается.
- Рецидив. Состояние наступает после ремиссии и характеризуется возвратом признаков заболевания с повышением уровня бластоза выше 5%. Выделяют ранний (с ремиссией менее года) и поздний (с ремиссией дольше года) рецидив острого лимфобластного лейкоза.
Иногда после нескольких ремиссий и рецидивов у пациента наступает терминальная стадия, при которой проводимая терапия не дает никаких результатов. После этого неизбежно наступает летальный исход. У большинства больных результаты лечения оказываются более благоприятными, и после ремиссии, как правило, происходит выздоровление.
Диагностика
Чтобы диагностировать острый лимфоцитарный лейкоз, необходим ряд лабораторных анализов и инструментальных исследований.
Общий анализ крови обязательно проводят с подсчетом лейкоцитарной формулы, чтобы выявить первичные признаки болезни.
Биохимический анализ крови проводят для уточнения состояния внутренних органов, в частности – печени и почек.
Биопсия костного мозга из подвздошной кости предоставляет материал для основных исследований.
Рентген грудной клетки необходим для выявления увеличенных лимфоузлов, а также для определения воспалительного процесса в легких.
В процессе лечения может появиться необходимость в дальнейших диагностических и мониторинговых исследованиях.
Вы можете бесплатно получить медицинскую помощь в АО «Медицина» (клиника академика Ройтберга) по программе по программе Государственных гарантий ОМС (Обязательного медицинского страхования) и ВМП (высокотехнологичной медицинской помощи).
Лечение
Стратегию лечения острого лимфобластного лейкоза разрабатывает и утверждает консилиум, в который входят медики нескольких специализаций: онколог общего профиля, химиотерапевт, радиолог, гематолог, другие специалисты. Как правило, пациенту назначают комплекс мероприятий, включающий наиболее эффективные методики.
Химиотерапия является ключевым методом при онкозаболеваниях крови и костного мозга. Современные препараты эффективно уничтожают злокачественные клетки либо угнетают их рост и деление. В зависимости от показаний, каждому пациенту разрабатывают индивидуальный курс с несколькими разными химиопрепаратами. Если они не оказывают желаемого эффекта, назначения корректируют с учетом новых данных.
Лучевая терапия используется в качестве вспомогательного метода при лечении некоторых подвидов заболевания. Наиболее часто она предшествует хирургической операции по пересадке костного мозга, когда требуется тотальное уничтожение опухолевых клеток.
Лечение состоит из нескольких этапов:
- подготовительного, необходимого для снижения количества лейкозных клеток в крови;
- индукции ремиссии – интенсивного курса, целью которого является максимально возможное уничтожение опухоли;
- консолидации, направленной на закрепление результата и уничтожение остаточных очагов;
- реиндукции, или повторении индукции, чтобы полностью исключить вероятность рецидива;
- поддерживающей терапии, которая при успешном лечении продолжается около двух лет и состоит из небольших доз цитостатиков.
Между этапами делаются перерывы, необходимые для восстановления организма после воздействия тяжелых препаратов.
Прогнозы
При остром лимфобластном лейкозе прогноз зависит, в первую очередь, от возраста пациента. У детей выздоровление наступает в 80-90% случаев. Для взрослых этот показатель в настоящее время составляет 40-45%, причем у более молодых пациентов шансы существенно выше, чем у людей старше 60 лет. Не следует забывать, что за последние годы онкологи добились существенных успехов в лечении заболеваний крови. Ежегодно появляются новые, все более эффективные и безопасные химиопрепараты направленного действия.
Профилактика
Специальных мер для предупреждения острого лимфоидного лейкоза не существует. Чтобы снизить риски заболевания, необходимо придерживаться здорового образа жизни, укреплять естественный иммунитет, избегать радиационных и канцерогенных воздействий.
Реабилитация
В течение реабилитационного периода пациент нуждается в полном восстановлении функций организма, для чего необходимо:
- поддерживать и укреплять иммунную систему;
- восстанавливать кишечную микрофлору;
- выводить из организма токсины, образовавшиеся после распада патогенных клеток;
- укреплять нервную систему, бороться со стрессами и депрессивными состояниями.
Диагностика и лечение острого лимфобластного лейкоза в Москве
Если у вас или члена вашей семьи обнаружены признаки острого лимфобластного лейкоза, обратитесь в клинику «Медицина». Мы предлагаем своим пациентам:
- лечение у онкологов, химиотерапевтов, гематологов высокой квалификации;
- диагностику с использованием новейшего медицинского оборудования;
- пребывание в комфортабельной палате стационара под круглосуточным наблюдением;
- медицинский сервис в соответствии с жесткими стандартами мировой медицины.
Позвоните нам, чтобы выяснить интересующие вас подробности и записаться на консультацию.
Вопросы и ответы
Сколько живут при остром лимфобластном лейкозе?
Заболевание отличается стремительным течением, поэтому без медицинской помощи летальный исход наступает в течение нескольких месяцев. При своевременно начатом лечении шансы прожить более 7 лет имеются у 80-90% детей и около 40% взрослых.
Сколько времени продолжается лечение острого лимфобластного лейкоза?
- Подготовительный этап лечения продолжается 1-2 недели.
- Индукция – до 8 недель.
- Консолидация – до 4 месяцев.
- Реиндукция – несколько месяцев.
- Поддерживающая терапия – до полутора лет.
Общая продолжительность лечения составляет примерно два или два с половиной года.
Как понять, что у тебя острый лимфобластный лейкоз?
Если у вас появились:
- симптомы общего недомогания – вялость, слабость, повышенная температура;
- кровотечения из носа, десен, других слизистых оболочек;
- плохо заживающие ранки на коже;
- сильная потливость по ночам –
необходимо как можно скорее обратиться к онкологу или гематологу и сделать анализы. Перечисленные симптомы далеко не всегда свидетельствуют о начале острого лимфобластного лейкоза, однако это заболевание развивается стремительно и агрессивно. Для успеха лечения дорог буквально каждый день.
Острый лимфоблстный лейкоз
Острый лимфобластный лейкоз (ОЛЛ, также называемый острый лимфолейкоз) представляет собой рак из крови и костного мозга. В норме костный мозг продуцирует кровеносные стволовые клетки (незрелые клетки ), которые со временем становятся зрелыми кровяными клетками. Стволовая клетка крови может стать миелоидной стволовой клеткой или лимфоидной стволовой клеткой.
Лимфоидная стволовая клетка становится лимфобластной клеткой, а затем одним из трех типов лимфоцитов(лейкоцитов):
- B лимфоциты,которые делают антитела, чтобы помочь бороться с инфекцией.
- Т-лимфоциты, которые помогают В-лимфоцитам, делают антитела, которые помогают бороться с инфекцией.
- Природные клетки-киллеры,которые поражают раковые клетки и вирусы.
При ОЛЛ слишком много стволовых клеток становятся лимфобластами, В-лимфоцитами или Т-лимфоцитами.
Ранние признаки и симптомы ОЛЛ могут быть похожи на грипп или другие распространенные заболевания. Проконсультируйтесь с вашим врачом, если у вас есть одно из следующих:
- Слабость или чувство усталости.
- Лихорадка или ночная потливость.
- Легкие кровоподтеки или кровотечения.
- Петехии (плоские, точечные пятна под кожей, вызванные кровотечением).
- Сбивчивое дыхание.
- Потеря веса или потеря аппетита.
- Боль в костях или желудке.
- Боль или ощущение полноты ниже ребер.
- Безболезненные глыбы в области шеи, подмышек, желудка или паха.
Диагностика:
- Физический осмотр и история;
- Общий анализ крови (ОАК) с подсчетом лейкофолрмулы и тромбоцитов;
- Биохимический анализ крови;
- Мазок периферической крови;
- Аспирация костного мозга и биопсия;
- Цитогенетический анализ;
- Иммунофенотипирование;
При ОЛЛ взрослых не существует стандартной системы стадирования. Болезнь описывается как нелеченая, ремиссия или рецидивирующая.
Вперые выявленные (нелеченая):
- Общий анализ крови ненормален.
- Более 20% клеток в костном мозге являются бластами (клетки лейкемии).
- Имеются признаки и симптомы лейкемии.
- Ремиссия (после проведения ХТ)
- Общий анализ крови нормальный.
- 5% или меньше бластных клеток в костном мозге (клетки лейкемии).
- Нет никаких признаков или симптомов лейкемии.
- При рецидивирующая форме ОЛЛ опухолевые клетки прогрессирует после ремиссии.
Существует разные виды лечения ОЛЛ взрослых.
Некоторые методы лечения являются стандартными (применяемое в настоящее время лечение), а некоторые из них проходят тестирование в клинических испытаниях. Клиническое исследование лечения – это исследование, которое можно использовать для лечения пациентов с онкологическими заболеваниями. Когда клинические испытания показывают, что новое лечение лучше стандартного лечения, новое лечение может стать стандартным лечением. Пациенты могут захотеть подумать о том, чтобы принять участие в клиническом испытании. Некоторые клинические испытания предназначены только для пациентов, которые не начали лечение.
Лечение ОЛЛ взрослых состоит из двух фаз:
Индукция ремиссии это первый этап лечения, направленная на уничтожения опухолевых клеток в костном мозге и крови.
Терапия после ремиссии второй этап лечения, она начинается после достижения ремисии. Цель терапии после ремиссии заключается в сдерживании лейкемических клеток.
Лечение центральной нервной системы (ЦНС) обычно назначается на каждом этапе терапии. Поскольку стандартные дозы химиотерапии не могут проникать в клетки лейкемии в ЦНС (клетки мозга и спинной мозг). Системная химиотерапия, получаемая в высоких дозах, интратекальная химиотерапия и лучевая терапия для мозга, способны проникать в клетки лейкемии в ЦНС. Лечебная терапия ЦНС также называется профилактикой нейролейкоза.
Используются 4 типа стандартных терапии при лечении ОЛЛ.
Химиотерапия – это лечение рака, которое использует лекарства, чтобы остановить рост раковых клеток, либо путем уничтожения клеток, либо путем прекращения их деления.
Лучевая терапия – это лечение рака, которое использует высокоэнергетические рентгеновские лучи или другие виды излучения для уничтожения раковых клеток или предотвращения их роста.
Химиотерапия с последующей трансплантацией ГСК.
Таргетная терапия – исползуется лекарства или другие субстраты которые уничтожают клетки лейкоза,
Острый миелобластный лейкоз (ОМЛ, также называемый острый миелолейкоз) представляет собой рак из крови и костного мозга.
Миелоидная стволовая клетка становится одним из трех типов зрелых клеток крови:
- Эритроциты,которые переносят кислород и другие вещества во все ткани организма.
- Тромбоциты, образующие сгустки крови,прекращают кровотечение.
- Гранулоциты(белые кровяные клетки ), которые борются с инфекцией и болезнями.
При ОМЛ миелоидные стволовые клетки обычно становятся незрелой клеткой крови, называемой миелобластами (или миелоидами). Миелобласты при ОМЛ являются ненормальными и не становятся зрелыми лейкоцитами. Клетки лейкоза могут накапливаться в костном мозге и крови, поэтому количество здоровых лейкоцитов, эритроцитов и тромбоцитов снижается.
Ранние признаки и симптомы ОМЛ могут быть похожи на грипп или другие распространенные заболевания. Проконсультируйтесь с вашим врачом, если у вас есть одно из следующих:
- Слабость или чувство усталости.
- Лихорадка или ночная потливость.
- Легкие кровоподтеки или кровотечения.
- Петехии (плоские, точечные пятна под кожей, вызванные кровотечением).
- Сбивчивое дыхание.
- Потеря веса или потеря аппетита.
- Боль в костях или желудке.
- Боль или ощущение полноты ниже ребер.
- Безболезненные глыбы в области шеи, подмышек, желудка или паха.
Диагностика:
- Физический осмотр и история;
- Общий анализ крови (ОАК) с подсчетом лейкофолрмулы и тромбоцитов;
- Биохимический анализ крови;
- Мазок периферической крови;
- Аспирация костноо мозга и биопсия;
- Цитогенетический анализ;
- Иммунофенотипирование;
При ОЛЛ взрослых не существует стандартной системы стадирования. Болезнь описывается как нелеченая, ремиссия или рецидивирующая.
Вперые выявленные (нелеченая):
- Общий анализ крови ненормален.
- Более 20% клеток в костном мозге являются бластами (клетки лейкемии).
- Имеются признаки и симптомы лейкемии.
- Ремиссия (после проведения ХТ)
- Общий анализ крови нормальный.
- 5% или меньше бластных клеток в костном мозге (клетки лейкемии).
- Нет никаких признаков или симптомов лейкемии.
- При рецидивирующая форме ОЛЛ опухолевые клетки прогрессирует после ремиссии.
Существует разные виды лечения ОМЛ взрослых.
Некоторые методы лечения являются стандартными (применяемое в настоящее время лечение), а некоторые из них проходят тестирование в клинических испытаниях. Клиническое исследование лечения – это исследование, которое можно использовать для лечения пациентов с онкологическими заболеваниями. Когда клинические испытания показывают, что новое лечение лучше стандартного лечения, новое лечение может стать стандартным лечением. Пациенты могут захотеть подумать о том, чтобы принять участие в клиническом испытании. Некоторые клинические испытания предназначены только для пациентов, которые не начали лечение.
Лечение ОМЛ взрослых состоит из двух фаз:
Индукция ремиссии это первый этап лечения, направленная на уничтожения опухолевых клеток в костном мозге и крови.
Консалидация ремиссии (терапия после ремиссии) второй этап лечения, она начинается после достижения ремисии. Цель терапии после ремиссии заключается в сдерживании лейкемических клеток.
Лечение центральной нервной системы (ЦНС) обычно назначается на каждом этапе терапии. Поскольку стандартные дозы химиотерапии не могут проникать в клетки лейкемии в ЦНС (клетки мозга и спинной мозг). Системная химиотерапия, получаемая в высоких дозах, интратекальная химиотерапия и лучевая терапия для мозга, способны проникать в клетки лейкемии в ЦНС. Лечебная терапия ЦНС также называется профилактикой нейролейкоза.
Используются 4 типа стандартных терапии при лечении ОЛЛ.
Химиотерапия – это лечение рака, которое использует лекарства, чтобы остановить рост раковых клеток, либо путем уничтожения клеток, либо путем прекращения их деления.
Лучевая терапия – это лечение рака, которое использует высокоэнергетические рентгеновские лучи или другие виды излучения для уничтожения раковых клеток или предотвращения их роста.
Химиотерапия с последующей трансплантацией ГСК.
Таргетная терапия – исползуется лекарства или другие субстраты которые уничтожают клетки лейкоза,
Хроническая лимфолейкоз (также называемая ХЛЛ) – это заболевание крови и костного мозга, которое обычно протекает медленно. ХЛЛ – один из самых распространенных видов лейкозов у взрослых. Часто это происходит во время или после среднего возраста; это редко встречается у детей.
При ХЛЛ слишком много стволовых клеток крови становятся аномальными лимфоцитами и не становятся зрелыми лимфоцитами. Лимфоциты не способны очень хорошо бороться с инфекцией. Кроме того, по мере увеличения количества лимфоцитов в крови и костном мозге меньше места для здоровых лейкоцитов, эритроцитов и тромбоцитов. Это может вызвать инфекцию, анемию и легкое кровотечение.
Факторам риска для ХЛЛ относится:
Мужчины средних и старших лет, белые.
Семейная история ХЛЛ или рак лимфатической системы.
Для того чтобы поставить диагноз хронического лимфолейкоза, необходимо осуществить следующие исследования:
- Врачебный осмотр
- Клинический анализ кровис подсчетом лейкоцитарной формулы
- Исследование костного мозгапозволяет выявить характерную для этого заболевания картину поражения.
- Иммунофенотипированиеклеток костного мозга и периферической крови выявляет специфические иммунологические маркеры, характерные для опухолевых клеток при хроническом лимфолейкозе.
- Биопсия пораженного лимфатического узла с его морфологическим и иммунологическим исследованием.
- Определение уровняβ 2-микроглобулина помогает прогнозировать течение заболевания.
- Цитогенетический анализпозволяет получить данные о характеристике опухолевых клеток, которые в ряде случаев имеют прогностическое значение.
- Определение уровня иммуноглобулиновпозволяет определить, насколько велик риск развития инфекционных осложнений у данного пациента.
В соответствии с современной системой стадирования хронического лимфолейкоза, предложенной Международной рабочей группой по хроническому лимфолейкозу, выделяют три стадии:
- Стадия А – лимфоцитоз при поражении не более 2-х групп лимфатических узлов (или в отсутствие их поражения); тромбоцитопения и анемия отсутствуют.
- Стадия В – поражены 3 и более группы лимфатических узлов; тромбоцитопения и анемия отсутствуют.
- Стадия С – наличие тромбоцитопении или анемии независимо от числа пораженных групп лимфатических узлов.
В зависимости от наличия тех или иных симптомов, к буквенному обозначению стадии хронического лимфолейкоза могут быть добавлены римские цифры:
I – при наличии лимфаденопатии
II – при увеличении селезенки (спленомегалии)
III – при наличии анемии
IV – при наличии тромбоцитопении
В отличие от многих других опухолей, считают, что при хроническом лимфолейкозе не целесообразно проведение терапии в ранних стадиях заболевания. Это обусловлено тем, что у большинства пациентов в начальных стадиях хронического лимфолейкоза заболевание носит “тлеющий” характер, и больные могут долгое время обходиться без лечения, нормально себя чувствуя и сохраняя привычный образ жизни. Лечение необходимо начинать лишь при появлении признаков прогрессирования заболевания, к которым относят:
- Быстрое нарастание числа лимфоцитов в крови
- Прогрессирующее увеличение лимфатических узлов
- Значительное увеличение селезенки
- Нарастание анемии и тромбоцитопении
- Появление симптомов опухолевой интоксикации – лихорадки, ночных потов, потери веса, выраженной слабости
Существует несколько подходов к лечению хронического лимфолейкоза:
- Химиотерапия препаратом хлорбутин до недавнего времени являлась стандартным методом лечения хронического лимфолейкоза. В настоящее время доказана более эффективно использование новой группы препаратов, так называемых пуриновых аналогов, представителем которой является Флудара.
- К эффективным методам лечения хронического лимфолейкоза относят биоиммунотерапию с применением моноклональных антител. Введение этих препаратов позволяет селективно уничтожать опухолевые клетки, не повреждая здоровые ткани организма.
- При неудовлетворительной эффективности других методов лечения, может быть осуществлена высокодозная химиотерапия с трансплантацией кроветворных стволовых клеток.
- Лучевая терапия применяется в качестве вспомогательного метода лечения при наличии большой опухолевой массы.
- ” Удаление селезенки (спленэктомия) иногда показана при значительном увеличении этого органа.
Волосатоклеточный лейкоз (ВКЛ) – редкое хроническое лимфопролиферативное заболевание, поражающее костный мозг и селезенку. Его субстратом являются лимфоидные клетки B-клеточного происхождения с характерной морфологией – крупные размеры, округлое ядро и тонкие выросты цитоплазмы, от которых и произошло название заболевания.
Клинические проявления ВКЛ могут варьировать от минимальных или вообще полностью отсутствовать (и тогда заболевание является случайной находкой при исследовании клинического анализа крови) до выраженных симптомов спленомегалии и цитопении. Для ВКЛ характерны лейкопения с нейтропенией и моноцитопенией, а также анемия и тромбоцитопения. В 95% случаев в крови пациентов обнаруживают характерные «волосатые» лимфоциты, но количество их может различаться. Типично увеличение селезенки — от незначительного до гигантского, однако встречаются варианты ВКЛ без спленомегалии.
Определенные факторы влияют на варианты лечения и прогноз (вероятность выздоровления):
- Количество волосатых (лейкозных) клеток и здоровых клеток крови в крови и костном мозге.
- Опухание селезенки.
- Существуют ли признаки или симптомы лейкемии, такие как инфекция.
- Является ли лейкемия рецидивирующей (возвращаться) после предыдущего лечения.
Используются пять типов стандартной терапии:
Наблюдение: наблюдают за состоянием пациента, не давая никакого лечения, пока не появятся клинические симптомы.
Химиотерапия – это лечение рака, когда химипрепараты принимают внутрь или вводят в вену или мышцу. Способ назначения химиотерапии зависит от типа и стадии лечения рака. Кладрибин и пентостатин являются противоопухолевыми препаратами, обычно используемыми для лечения волосатоклеточного лейкоза.
Биологическая терапия – это лечение рака, которое использует иммунную систему пациента для борьбы с раком. Этот тип лечения рака также называется биотерапией или иммунотерапией. Интерферон альфа – биологический агент, обычно используемый для лечения волосатоклеточного лейкоза.
Хирургия Спленэктомия – это хирургическая процедура удаления селезенки.
Таргетная терапия – это лечение, которое использует лекарственные препараты для идентификации и атаки конкретных раковых клеток без ущерба для нормальных клеток.
Лимфобластный лейкоз
Лимфобластный лейкоз – это злокачественное заболевание крови и костного мозга. Оно характеризуется накоплением в лимфатических узлах, костном мозге и периферической крови опухолевых лимфоцитов. Другое название – лимфолейкоз. Свое развитие это заболевание начинает в костном мозге, своеобразной «фабрике» клеток крови.
Пока процесс кроветворения проходит нормально, «фабрика» производит полноценные клетки. А при сбое начинается выпуск огромного количества незрелых белых кровяных телец – лейкоцитов. У больного необходимые для нормальной жизнедеятельности клетки остаются незрелыми, они не развиваются и не способны защитить организм человека от инфекций.
Острый лимфобластный лейкоз у взрослых
Относительно недавно он считался «детским» заболеванием ввиду подверженности ему преимущественно маленьких пациентов в возрасте двух-четырех лет. В настоящее время наблюдается и среди взрослых.
Точные причины заболевания ученым до сих пор неизвестны.
Но существуют определенные факторы риска, в числе которых:
- возраст;
- половая принадлежность (у мужчин заболевание встречается чаще, чем у женщин);
- принадлежность к белой расе, (темнокожие меньше подвержены этому заболеванию);
- пройденное ранее лечение онкологических заболеваний и облучение;
- наличие генетических нарушений (Синдром Дауна).
Симптомы
Ранние симптомы лимфолейкоза характеризуются признаками, которые могут быть похожими на грипп, любые другие инфекционные заболевания и гематологические заболевания. Необходимо проконсультироваться с врачом, если любой из нижеперечисленных симптомов у вас проявляется часто:
- быстрая утомляемость, слабость и сонливость в течение дня;
- извращение вкуса (тяга к продуктам, которые раньше не нравились), отсутствие аппетита;
- резкая и беспричинная на первый взгляд потеря веса;
- одышка;
- неестественная бледность;
- повышенная температура;
- боли в суставах, в животе;
- множественные гематомы, появляющиеся спонтанно, частые кровотечения;
- чувство распирания в зоне ниже ребер;
- увеличивающиеся лимфоузлы на шее, подмышках, животе или в паху.
Хронический лимфобластный лейкоз характеризуется длительным отсутствием признаков качественного изменения в поведении опухолевых клеток при проводимом лечении. Хроническая форма этого недуга относится к одному из наиболее распространенных онкогематологических заболеваний. Также это наиболее частый вариант рака крови среди представителей европеоидной расы. Не совсем обычным клиническим проявлением этого заболевания может быть гиперреактивность человека в ответ на укусы насекомых.
Т-клеточный острый лимфобластный лейкоз
Хронический лимфолейкоз, представленный Т-лимфоцитами, встречается примерно в 5% случаев.
Это опухоль из лимфоцитов CD4, вызванная Т-лимфотропным вирусом человека типа 1 (HTLV-I). Заболевание проявляется генерализованным (распространяющимся по всему организму) увеличением лимфоузлов и поражением кожи. Из-за иммунодефицита очень высока частота вторичных инфекций.
Мужчины болеют чаще, чем женщины. Для лечения применяют различные комбинации противоопухолевых средств.
Прогноз
Без лечения лимфолейкоз может привести к гибели больного в течение нескольких месяцев или даже недель. При своевременном обращении примерно у 40-50% взрослых больных удается достичь стойкой ремиссии – то есть отсутствия рецидивов онкологического заболевания в течение пяти и более лет, после чего человека можно считать здоровым.

Лечение
На сегодняшний день существует несколько способов лечения острого лейкоза:
- химиотерапия – терапия сильнодействующими химиопрепаратами. Лекарства могут приниматься перорально (в виде таблеток, капсул) или же больному вводятся внутривенные или внутримышечные инъекции;
- лучевая терапия – способ лечения рака, при котором врач использует рентгеновское излучение или другие виды радиационных излучений;
- трансплантация стволовых клеток, которая применяется для замещения патологических кровообразующих клеток полноценными.
Все эти способы с успехом применяются в международном медицинском центре ОН КЛИНИК, где за годы работы высококвалифицированные врачи спасли тысячи жизней больных лимфобластным лейкозом.
Острый лимфобластный лейкоз
Острый лимфобластный лейкоз\лимфома (ОЛЛ)– опухолевая болезнь крови, при которой появляются быстро размножающиеся лимфоидные клетки-бласты. (О клетках-бластах мы уже рассказали в главе «Острый лейкоз».)
Симптомы острого лимфобластного лейкоза очень разнообразны. Часто пациент жалуется на слабость, ночную потливость, «ломоту» во всем теле, сильную головную боль; бывают и другие жалобы. При обследовании врач обнаруживает, что у пациента могут быть увеличены печень, селезенка, лимфатические узлы и есть опухолевые клетки-бласты в анализе крови.
Диагноз
Чтобы поставить диагноз, необходимо сделать анализ крови или костного мозга, который называется «проточная цитометрия бластов». Если у пациента есть увеличенные лимфатические узлы, то чтобы поставить диагноз берут его фрагмент для морфологического и и иммуногистохимического исследования. Если заболевание проявляется только увеличением лимфатических узлов, то врачи называют данное состояние «лимфобластной лимфомой». Если же у пациента опухолевые клетки находят в костном мозге, то ставят диагноз «острый лимфобластный лейкоз». Когда врач-морфолог выдает заключение по результатам исследования лимфатического узла, то диагноз он пишет иногда через косую черту, указывая оба заболевания. Это допустимо потому, что прогноз и лечение у этих заболеваний одинаковые. Более точный диагноз ставит лечащий врач на основании всей полноты анализов пациента.
В медицинских документах, записывая диагноз, врачи указывают из каких клеток происходит данный лейкоз (В- или Т-клеточный). Диагноз «лейкоз» сам по себе очень серьезен, но исключительно важными признаками, предсказывающими течение болезни, являются генетические поломки в опухолевых клетках. Их наблюдают и описывают врачи-цитогенетики во время цитогенетического исследования.
Лечение
Лимфобластные лейкозы лечат химиотерапией. Ее можно разделить на 3 этапа: это индукция, консолидация и поддержка. Результатом индукционного этапа должен стать полный ответ (полная ремиссия), то есть можно сказать, что пациент стал «временно здоров». Это означает, что подавляющее большинство опухолевых клеток погибло, самочувствие больного значительно улучшилось, но осталось немного «спящих» опухолевых клеток, поэтому лечение нужно продолжать. Если полный ответ достигнут, то следующий этап называется «консолидация», или закрепление достигнутого результата. Как правило, консолидирущую, или «закрепительную», химиотерапию пациент переносит лучше, хотя состоит она из больших доз химиопрепаратов. В дальнейшем отдельным больным проводят несколько курсов поддерживающей терапии, чтобы небольшими дозами химиопрепаратов уничтожить оставшиеся опухолевые клетки. Несмотря на то, что чаще всего на начальных этапах химиотерапия действует хорошо и большинство пациентов достигают полного ответа, к некоторым пациентам болезнь возвращается, и у таких больных развивается рецидив. Если риск рецидива высок, то чтобы его избежать, молодым пациентам проводят пересадку стволовых клеток крови. Отметим, что, когда в крупных городах России открыли центры трансплантации стволовых клеток крови, результаты лечения наших пациентов значительно улучшились. Они стали такими же, как в гематологических центрах Северной Америки и Европы.
Читайте также:
